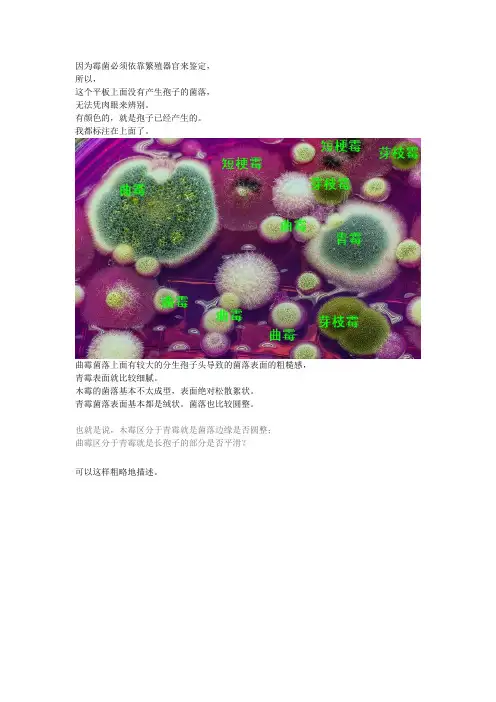

最新常见曲霉菌鉴定图片
- 格式:doc
- 大小:892.50 KB
- 文档页数:15




几种曲霉的形态特征常见曲霉困鉴定:菌落:菌落生长速度,表面质地、颜色、形态和气味等。
其中颜色是曲霉菌分类 的依据之一② 分生抱子头:分生抱子头的形状、颜色和大小。
分生抱子头由顶囊、瓶梗、梗 基和分生抱子链组成,为曲霉的特征性结构③ 分生抱子梗或分生抱子柄:注意分生抱子梗的长短、颜色、表面粗糙或光滑、 是否有隔等1、烟曲霉困在SDA 培养基上菌落生长快,棉花 样,开始为白色,2~3天后转为绿 色, 数日后变为深绿色,呈粉末 状。
分生抱子头的顶囊烧瓶状,小 梗单层,排列成 木栅状,布满顶囊 表面3/4,顶端有链形分生抱子,分生抱子球形,有小棘, 绿色烟曲霉菌菌落2、黄曲霉菌④ 具有性生殖的曲霉能产生闭囊壳:为封闭式的薄壁子囊果,含子囊和子囊抱子; ⑤足细胞,也为曲霉的特征性结构。
曲霉菌的结构在SDA培养基上菌落生长快,黄色,表面粉末状。
分生抱子头顶囊球形或近球形,小梗双层,第一层长,布满顶囊表面,呈放射状排列,黄色,顶端有链形抱子黄曲霉菌菌落黄曲霉菌分生抱子头3、土曲霉困在SDA培养基上菌落生长快,小,圆形,淡褐色或褐色。
分生抱子头的顶囊半球形,小梗双层,第一层短,第二层长,呈放射状排列,分布顶囊表面2/3,顶端有链形抱子土曲霉菌落F列图片为分生抱子头4、黑曲霉困在SDA培养基上菌落生长快,表面黑色,粉末状。
分生抱子头的顶囊球形或近球形,小梗双层,第一层粗大,第二层短小,呈放射状排列,布满整个顶囊,黑色,顶端有链形抱子黑曲霉菌洛黑曲霉分生抱子头5、杂色曲霉困在SDA培养基上菌落生长慢,菌落圆形紧密,绒毛状,羊毛状,颜色有数环,从青绿到红绿。
分生抱子头的顶囊近球形,小梗双层,第一层长,第二层短, 呈放射状排列,布满顶囊4/5 ,顶端有链形抱子杂色曲霉菌菌落杂色曲霉菌分生抱子头下图为杂色曲霉菌分生抱子头电镜。



【转帖】常见曲霉菌鉴定真菌2006-11-25 17:13:51 阅读798 评论2 字号:大中小订阅作者:龙太郎鉴定依据:①菌落:菌落生长速度,表面质地、颜色、形态和气味等。
其中颜色是曲霉菌分类的依据之一②分生孢子头:分生孢子头的形状、颜色和大小。
分生孢子头由顶囊、瓶梗、梗基和分生孢子链组成,为曲霉的特征性结构③分生孢子梗或分生孢子柄:注意分生孢子梗的长短、颜色、表面粗糙或光滑、是否有隔等④具有性生殖的曲霉能产生闭囊壳:为封闭式的薄壁子囊果,含子囊和子囊孢子;⑤足细胞,也为曲霉的特征性结构。
曲霉菌的结构:1、烟曲霉菌在SDA培养基上菌落生长快,棉花样,开始为白色,2~3天后转为绿色,数日后变为深绿色,呈粉末状。
分生孢子头的顶囊烧瓶状,小梗单层,排列成木栅状,布满顶囊表面3/4,顶端有链形分生孢子,分生孢子球形,有小棘,绿色:烟曲霉菌菌落:下列图片为烟曲霉分生孢子头:2、黄曲霉菌:在SDA培养基上菌落生长快,黄色,表面粉末状。
分生孢子头顶囊球形或近球形,小梗双层,第一层长,布满顶囊表面,呈放射状排列,黄色,顶端有链形孢子。
黄曲霉菌菌落:黄曲霉菌分生孢子头:3、土曲霉菌在SDA培养基上菌落生长快,小,圆形,淡褐色或褐色。
分生孢子头的顶囊半球形,小梗双层,第一层短,第二层长,呈放射状排列,分布顶囊表面2/3,顶端有链形孢子。
土曲霉菌落:土曲霉分生孢子头:4、黑曲霉菌在SDA培养基上菌落生长快,表面黑色,粉末状。
分生孢子头的顶囊球形或近球形,小梗双层,第一层粗大,第二层短小,呈放射状排列,布满整个顶囊,黑色,顶端有链形孢子。
黑曲霉菌落:黑曲霉分生孢子头:5、杂色曲霉菌在SDA培养基上菌落生长慢,菌落圆形紧密,绒毛状,羊毛状,颜色有数环,从青绿到红绿。
分生孢子头的顶囊近球形,小梗双层,第一层长,第二层短,呈放射状排列,布满顶囊4/5,顶端有链形孢子。
杂色曲霉菌菌落:杂色曲霉菌分生孢子头:杂色曲霉菌分生孢子头电镜下图片:6、构巢曲霉菌在SDA培养基上菌落暗绿色,中央呈粉末状,边缘绒毛状。

曲霉的鉴定方法
曲霉的鉴定主要包括培养和镜检两个步骤。
在培养方面,曲霉菌落生长快,黑色或黑褐色,1-4天即可进行鉴定。
顶囊球形或近球形,小梗双层、密生于顶囊全部表面。
在镜检方面,应注意与亮白曲霉进行区分,后者菌落颜色为白色,生长慢。
幼龄时黄色菌落注意与黄曲霉相区分:前者菌落表面黄色颗粒稀疏、为淡黄色,后者黄色颗粒较粗、密,为金黄色,两者镜下差异显著。
此外,曲霉菌广泛分布于世界各地的粮食、植物性产品和土壤中,是重要的发酵工业菌种,可生产淀粉酶、酸性蛋白酶、纤维素酶、果胶酶、葡萄糖氧化酶、柠檬酸、葡糖酸和没食子酸等。
有的菌株还可将羟基孕甾酮转化为雄烯。
总的来说,曲霉的鉴定需要综合考虑其培养和镜检特征,以及其在不同环境中的分布和生长情况。
因为霉菌必须依靠繁殖器官来鉴定,
所以,
这个平板上面没有产生孢子的菌落,
无法凭肉眼来辨别。
有颜色的,就是孢子已经产生的。
我都标注在上面了。
曲霉菌落上面有较大的分生孢子头导致的菌落表面的粗糙感,青霉表面就比较细腻。
木霉的菌落基本不太成型,表面绝对松散絮状。
青霉菌落表面基本都是绒状。
菌落也比较圆整。
也就是说,木霉区分于青霉就是菌落边缘是否圆整;
曲霉区分于青霉就是长孢子的部分是否平滑?
可以这样粗略地描述。
常见曲霉菌鉴定图片
1、烟曲霉菌
在SDA培养基上菌落生长快,棉花样,开始为白色,2-3天后转为绿色,数日后变为深绿色,呈粉末状。
分生孢子头的顶囊烧瓶状,小梗单层,排列成木栅状,布满顶囊表面3/4,顶端有链形分生孢子,分生孢子球形,有小棘,绿色
2、烟曲霉菌菌落
下列图片为烟曲霉分生孢子头
本帖最后由乐园于 2011-5-18 23:10 编辑
2、黄曲霉菌
在SDA培养基上菌落生长快,黄色,表面粉末状。
分生孢子头顶囊球形或近球形,小梗双层,第一层长,布满顶囊表面,呈放射状排列,黄色,顶端有链形孢子
黄曲霉菌菌落
本帖最后由乐园于 2011-5-18 23:14 编辑
3、土曲霉菌
在SDA培养基上菌落生长快,小,圆形,淡褐色或褐色。
分生孢子头的顶囊半球形,小梗双层,第一层短,第二层长,呈放射状排列,分布顶囊表面2/3,顶端有链形孢子
下载 (20.93 KB)
2011-5-18 23:14
土曲霉菌落
下列图片为分生孢子头
4、黑曲霉菌
在SDA培养基上菌落生长快,表面黑色,粉末状。
分生孢子头的顶囊球形或近球形,小梗双层,第一层粗大,第二层短小,呈放射状排列,布满整个顶囊,黑色,顶端有链形孢子
黑曲霉菌落、
黑曲霉分生孢子头
5、杂色曲霉菌
在SDA培养基上菌落生长慢,菌落圆形紧密,绒毛状,羊毛状,颜色有数环,从青绿到红绿。
分生孢子头的顶囊近球形,小梗双层,第一层长,第二层短,呈放射状排列,布满顶囊4/5,
顶端有链形孢子
杂色曲霉菌菌落
下载 (12.66 KB) 2011-5-18 23:23
杂色曲霉菌分生孢子头
下图为杂色曲霉菌分生孢子头电镜
6、构巢曲霉菌
在SDA培养基上菌落暗绿色,中央呈粉末状,边缘绒毛状。
分生孢子头的顶囊半球形,小梗双层,第一层短,第二层长,呈放射状排列,布顶囊1/2,顶端有链形孢子
构巢曲霉菌落
构巢曲霉分生孢子头。